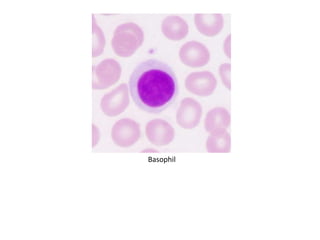
Basophil
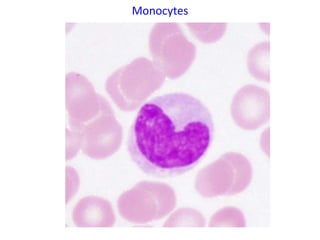
Monocytes
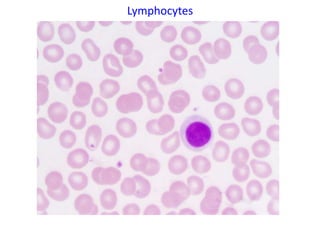
Lymphocytes

This document discusses the toxicology of leukocytes, including their components, functions, and toxic effects. It covers the kinetics, morphology, and interpretation of changes to neutrophils, eosinophils, basophils, monocytes, and lymphocytes. Important topics include mechanisms of neutrophilic leukocytosis, idiosyncratic toxic neutropenia, phagocyte function, the eosinophilia-myalgia syndrome, and causes of changes in the different leukocyte types.